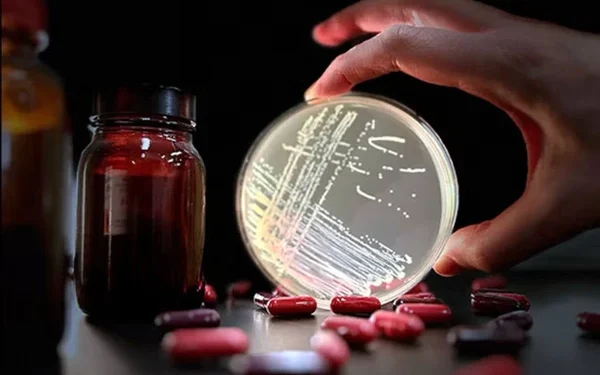
Common Antibiotics May Cause Superbugs, Research

A common antibiotic drug used to treat liver disease may cause a nearly incurable superbug, scientists warn in a new study.
According to an eight-year study (published in the journal Nature), the antibiotic rifaximin has caused a global outbreak of vancomycin-resistant Enterococcus faecium (VRE). VRE is a superbug that continues to cause serious infections in hospitalized patients.
An international team of researchers has warned that rifaximin is leading to bacterial resistance to daptomycin. Daptomycin is one of the last effective treatments against VRE infections.
The research findings challenge the long-held view that rifaximin has a low risk of causing antibiotic resistance.
Researchers have emphasized the need for a better understanding of the adverse effects of antibiotic use and the responsible use of these drugs.